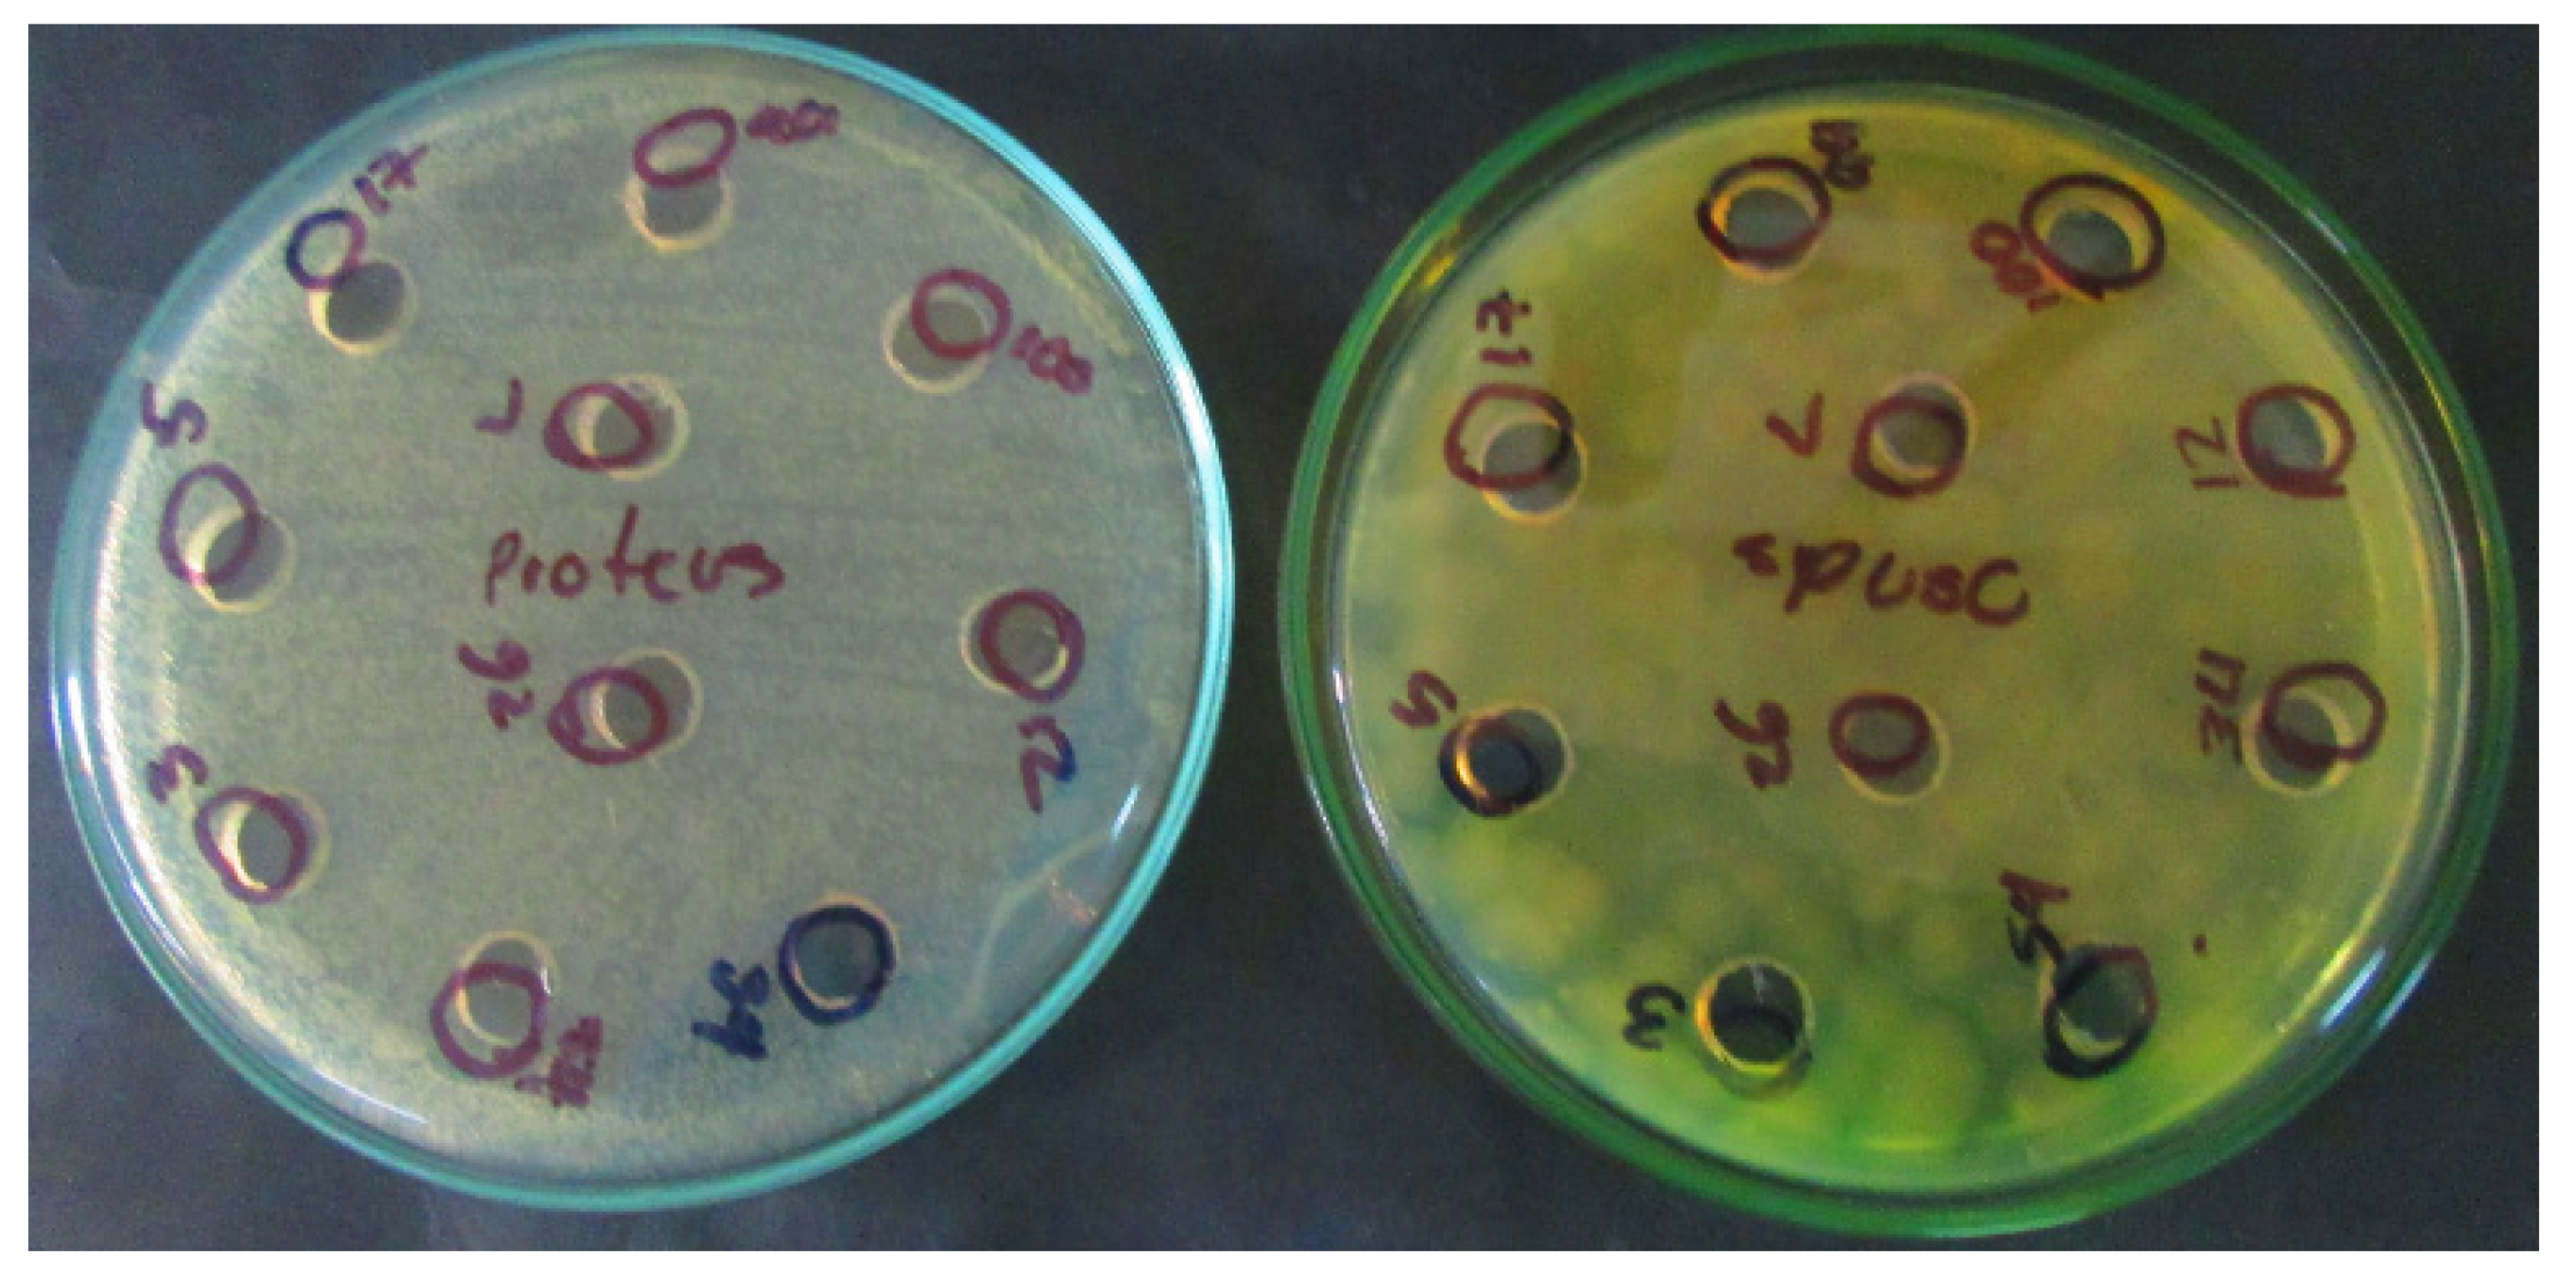
Processes 09 01582 g004

Potential Use of Lactic Acid Bacteria with Pathogen Inhibitory Capacity as a Biopreservative Agent for Chorizo
Abstract
1. Introduction
2. Materials and Methods
2.1. Viability at Different Concentrations of NaCl, Nitrate and Nitrate Salts and Different pH Values and Temperatures
2.2. Antibiotic Resistance
2.3. Lactic Acid Isomers
2.4. Antimicrobial Activity Test
2.5. Identification of Inhibitory Substances
2.5.1. Identification of the Inhibitory Substance by the Agar Well Diffusion Method
2.5.2. Qualitative and Quantitative Estimation of Organic Acids Produced by the Isolates through HPLC
2.5.3. Purification and Enzyme Assay of Crude Cell Extracts
2.6. Meat Mass Testing
Production of Cooked Chorizo
3. Results
3.1. Viability at Different Concentrations of NaCl, Nitrite and Nitrate Salts, pH Values and Temperatures
3.1.1. Tolerance of LAB to Different NaCl Concentrations
3.1.2. Tolerance of LAB to Different Concentrations of Nitrate and Nitrate Salts
3.1.3. Viability at Different pH Concentrations
3.1.4. Viability at Different Temperatures
3.1.5. Antibiotic Resistance and Type of Lactic Acid
3.2. Inhibition Testing of Selected Isolates
3.3. Identification of Inhibitory Substances
3.3.1. Identification of Inhibitory Substances Using the Agar Well Diffusion Method
3.3.2. Qualitative and Quantitative Estimation of Organic Acids Produced by the Isolates Detected by HPLC
3.3.3. Purification and Enzyme Assay of Crude Cell Extracts
3.4. Meat Mass Testing
Determination of the Microbiological Characteristics of Chorizo
4. Discussion
5. Conclusions
6. Recommendations
Author Contributions
Funding
Institutional Review Board Statement
Informed Consent Statement
Data Availability Statement
Acknowledgments
Conflicts of Interest
References
- Akbar, A.; Ali, I.; Anal, A.K. Industrial Perspetives of Lactic Acid Bateria for Biopreservation and food safety. J. Anim. Plant Sci. 2016, 26, 938–948. [Google Scholar]
- Rahmeh, R.; Akbar, A.; Kishk, M.; Al-Onaizi, T.; Al-Azmi, A.; Al-Shatti, A.; Shajan, A.; Al-Mutairi, S.; Akbar, B. Distribution and antimicrobial activity of lactic acid bacteria from raw camel milk. New Microbes New Infect. 2019, 30, 100560. [Google Scholar] [CrossRef] [PubMed]
- Trias, R.; Bañeras, L.; Montesinos, E.; Badosa, E. Lactic acid bacteria from fresh fruit and vegetables as biocontrol agents of phytopathogenic bacteria and fungi. Int. Microbiol. 2008, 11, 231–236. [Google Scholar] [CrossRef] [PubMed]
- Yépez, A.; Luz, C.; Meca, G.; Vignolo, G.; Mañes, J.; Aznar, R. Biopreservation potential of lactic acid bacteria from Andean fermented food of vegetal origin. Food Control 2017, 78, 393–400. [Google Scholar] [CrossRef]
- Velázquez-López, A.; Covatzin-Jirón, D.; Toledo-Meza, M.D.; Gutierrez, G.V. Bebida fermentada elaborada con bacterias ácido lácticas aisladas del pozol tradicional chiapaneco Fermented drink elaborated with lactic acid bacteria isolated from chiapaneco traditional pozol. CienciaUAT 2018, 13, 165–178. [Google Scholar] [CrossRef]
- Jones, R.J.; Hussein, H.M.; Zagorec, M.; Brightwell, G.; Tagg, J.R. Isolation of lactic acid bacteria with inhibitory activity against pathogens and spoilage organisms associated with fresh meat. Food Microbiol. 2008, 25, 228–234. [Google Scholar] [CrossRef]
- Federici, S.; Ciarrocchi, F.; Campana, R.; Ciandrini, E.; Blasi, G.; Baffone, W. Identification and functional traits of lactic acid bacteria isolated from Ciauscolo salami produced in Central Italy. Meat Sci. 2014, 98, 575–584. [Google Scholar] [CrossRef]
- Prabhurajeshwar, C.; Chandrakanth, K. Evaluation of antimicrobial properties and their substances against pathogenic bacteria in-vitro by probiotic Lactobacilli strains isolated from commercial yoghurt. Clin. Nutr. Exp. 2019, 23, 97–115. [Google Scholar] [CrossRef]
- Gänzle, M. Lactic metabolism revisited: Metabolism of lactic acid bacteria in food fermentations and food spoilage. Curr. Opin. Food Sci. 2015, 2, 106–117. [Google Scholar] [CrossRef]
- Rahman, U.U.; Khan, M.I.; Sohaib, M.; Sahar, A.; Ishaq, A. Exploiting microorganisms to develop improved functional meat sausages: A review. Food Rev. Int. 2016, 33, 195–215. [Google Scholar] [CrossRef]
- Lopez, M.C.V.; Canencio, J.A.O.; Acuña, P.A.G.; Durango, A.C. Bacterias Acido Lácticas (Bal) Como Alternativa de Conservación de la Carne de Res Empacada en Atmósfera Modificada. Aliment. Hoy 2011, 20, 18–27. [Google Scholar]
- Zannini, E.; Waters, D.M.; Coffey, A.; Arendt, E.K. Production, properties, and industrial food application of lactic acid bacteria-derived exopolysaccharides. Appl. Microbiol. Biotechnol. 2016, 100, 1121–1135. [Google Scholar] [CrossRef]
- Ayyash, M.; Abushelaibi, A.; Al-Mahadin, S.; Enan, M.; El-Tarabily, K.; Shah, N. In-vitro investigation into probiotic characterisation of Streptococcus and Enterococcus isolated from camel milk. LWT 2018, 87, 478–487. [Google Scholar] [CrossRef]
- Burgos, M.J.G.; López, R.L.; Aguayo, M.C.L.; Pulido, R.P.; Gálvez, A. Bioconservación de Alimentos Cárnicos. Real Acad. Cienc. Vet. Andal. Orient. 2011, 24, 111–123. [Google Scholar]
- Deshmukh, P.V.; Thorat, P.R. Bacteriocins: A new trend in antimicrobial food packaging. Int. J. Adv. Res. Eng. Appl. Sci. 2013, 2, 1–12. [Google Scholar]
- Jurado-Gámez, H.; Gúzman-Insuasty, M.; Jarrín-Jarrín, V. Determinación de la cinética, pruebas de crecimiento y efecto de inhibición in vitro de Lactobacillus lactis en Staphylococcus aureus, Staphylococcus epidermidis, Streptococcus agalactiae y Escherichia coli. Rev. Fac. Med. Vet. Zootec. 2015, 62, 23–39. [Google Scholar] [CrossRef]
- Blanco, L. Diseño de dos Modelos de Conservación en Productos Cárnicos, Fundamentados en la Sustitución Total o Parcial de Nitrito–Nitrato. Ph.D. Thesis, Universidad de La Sabana, Bogota, Colombia, 2016. [Google Scholar]
- García-Díez, J.; Saraiva, C. Use of Starter Cultures in Foods from Animal Origin to Improve Their Safety. Int. J. Environ. Res. Public Health 2021, 18, 2544. [Google Scholar] [CrossRef] [PubMed]
- Da Costa, R.J.; Voloski, F.L.S.; Mondadori, R.G.; Duval, E.H.; Fiorentini, Â.M. Preservation of Meat Products with Bacteriocins Produced by Lactic Acid Bacteria Isolated from Meat. J. Food Qual. 2019, 2019, 4726510. [Google Scholar] [CrossRef]
- Maye, B.R.; Guzman, M. El Antibiograma de discos. Normalización de la técnica de Kirby-bauer. Biomédica 1984, 4, 112–121. [Google Scholar] [CrossRef][Green Version]
- Botero SP, B.; Gamboa DC, V.; Escobar GA, B.; Toro, C.R. Detección de isó-meros del ácido láctico: Metabolitos de bacterias ácido lácticas aisladas de masas ácidas fermentadas colom-bianas. Rev. Argent. Microbiol. 2013, 45, 205–206. Available online: http://www.scielo.org.ar/scielo.php?script=sci_arttext&pid=S0325-75412013000300012&lng=es&nrm=iso&tlng=es (accessed on 28 July 2021).
- Angmo, K.; Kumari, A.; Savitri; Bhalla, T.C. Probiotic characterization of lactic acid bacteria isolated from fermented foods and beverage of Ladakh. LWT 2016, 66, 428–435. [Google Scholar] [CrossRef]
- Cenicaña—Centro de Investigación de la Caña de Azúcar. Estación Experimetnal. Determinación de Ácidos Orgánicos, Glicerol y Etanol Empleando Cromatografía HPLC-UV/IR; Protocolo de Trabajo Cali; Cenicaña: Cali, Colombia, 2015. [Google Scholar]
- Padmavathi, T.; Bhargavi, R.; Priyanka, P.R.; Niranjan, N.R.; Pavitra, P.V. Screening of potential probiotic lactic acid bacteria and production of amylase and its partial purification. J. Genet. Eng. Biotechnol. 2018, 16, 357–362. [Google Scholar] [CrossRef]
- Ajao, O.; Banwo, K.; Ogunremi, O.; Sanni, A. Antimicrobial properties and probiotic potentials of lactic acid bacteria isolated from raw beef in ibadan, nigeria. J. Microbiol. Biotechnol. Food Sci. 2018, 8, 770–773. [Google Scholar] [CrossRef]
- Bungenstock, L.; Abdulmawjood, A.; Reich, F. Evaluation of antibacterial properties of lactic acid bacteria from traditionally and industrially produced fermented sausages from Germany. PLoS ONE 2020, 15, e0230345. [Google Scholar] [CrossRef]
- Leroy, F.; Verluyten, J.; De Vuyst, L. Functional meat starter cultures for improved sausage fermentation. Int. J. Food Microbiol. 2006, 106, 270–285. [Google Scholar] [CrossRef]
- Yazgan, H.; Kuley, E.; Gökmen, T.G.; Regenstein, J.M.; Özogul, F. The antimicrobial properties and biogenic amine production of lactic acid bacteria isolated from various fermented food products. J. Food Process. Preserv. 2021, 45, e15085. [Google Scholar] [CrossRef]
- Castro, M.; Palavecino, N.; Herman, C.; Garro, O.; Campos, C. Lactic acid bacteria isolated from artisanal dry sausages: Characterization of antibacterial compounds and study of the factors affecting bacteriocin production. Meat Sci. 2011, 87, 321–329. [Google Scholar] [CrossRef]
- Swetwiwathana, A.; Visessanguan, W. Potential of bacteriocin-producing lactic acid bacteria for safety improvements of traditional Thai fermented meat and human health. Meat Sci. 2015, 109, 101–105. [Google Scholar] [CrossRef] [PubMed]
- Martínez, A.C.; De Chihuahua, U.; Estrada-Gandarilla, M.; Monterrubio, A.L.R.; Acevedo, M.A.G. Prevalence of Lactic Acid Bacteria in Sliced Cooked Ham as an Indicator of Its Shelf Life. Rev. Vitae 2016, 23, 167–172. [Google Scholar] [CrossRef]
- Das, P.; Khowala, S.; Biswas, S. In vitro probiotic characterization of Lactobacillus casei isolated from marine samples. LWT 2016, 73, 383–390. [Google Scholar] [CrossRef]
- Todorov, S.D.; Stojanovski, S.; Iliev, I.; Moncheva, P.; Nero, L.A.; Ivanova, I.V. Technology and safety assessment for lactic acid bacteria isolated from traditional Bulgarian fermented meat product “lukanka”. Braz. J. Microbiol. 2017, 48, 576–586. [Google Scholar] [CrossRef]
- Patil, A.; DiSouza, J.; Pawar, S. Shelf life stability of encapsulated lactic acid bacteria isolated from sheep milk thrived in different milk as natural media. Small Rumin. Res. 2019, 170, 19–25. [Google Scholar] [CrossRef]
- Françoise, L. Occurrence and role of lactic acid bacteria in seafood products. Food Microbiol. 2010, 27, 698–709. [Google Scholar] [CrossRef] [PubMed]
- Di Maso, M.; Talamini, R.; Bosetti, C.; Montella, M.; Zucchetto, A.; Libra, M.; Negri, E.; Levi, F.; La Vecchia, C.; Franceschi, S.; et al. Red meat and cancer risk in a network of case–control studies focusing on cooking practices. Ann. Oncol. 2013, 24, 3107–3112. [Google Scholar] [CrossRef] [PubMed]
- Szymański, P.; Łaszkiewicz, B.; Kern-Jędrychowska, A.; Siekierko, U.; Kołożyn-Krajewska, D. The Use of the Mixed Bacteria Limosilactobacillus fermentum and Staphylococcus carnosus in the Meat Curing Process with a Reduced Amount of Sodium Nitrite. Appl. Sci. 2021, 11, 904. [Google Scholar] [CrossRef]
- Singhal, N.; Singh, N.S.; Mohanty, S.; Singh, P.; Virdi, J.S. Evaluation of Probiotic Characteristics of Lactic Acid Bacteria Isolated from Two Commercial Preparations Available in Indian Market. Indian J. Microbiol. 2019, 59, 112–115. [Google Scholar] [CrossRef]
- Favaro, L.; Todorov, S. Bacteriocinogenic LAB Strains for Fermented Meat Preservation: Perspectives, Challenges, and Limitations. Probiotics Antimicrob. Proteins 2017, 9, 444–458. [Google Scholar] [CrossRef]
- Păcularu-Burada, B.; Georgescu, L.A.; Vasile, M.A.; Rocha, J.M.; Bahrim, G.-E. Selection of Wild Lactic Acid Bacteria Strains as Promoters of Postbiotics in Gluten-Free Sourdoughs. Microorganisms 2020, 8, 643. [Google Scholar] [CrossRef]
- Aquilanti, L.; Garofalo, C.; Osimani, A.; Silvestri, G.; Vignaroli, C.; Clementi, F. Isolation and Molecular Characterization of Antibiotic-Resistant Lactic Acid Bacteria from Poultry and Swine Meat Products. J. Food Prot. 2007, 70, 557–565. [Google Scholar] [CrossRef]
- Mejri, L.; Hassouna, M. Characterization and selection of Lactobacillus plantarum species isolated from dry fermented sausage reformulated with camel meat and hump fat. Appl. Biol. Chem. 2016, 59, 533–542. [Google Scholar] [CrossRef]
- del Campo, C.I.M.; Gómez, H.E. Bacteias Ácido Lácticas Con Capaciadad Antagónica y Actividad Bac-tiocinogénica Aisladas de Queos Fresco. e-Gnosis 2008, 6, 1–17. Available online: https://www.redalyc.org/articulo.oa?id=73011197005 (accessed on 28 July 2021).
- Georgieva, R.; Yocheva, L.; Tserovska, L.; Zhelezova, G.; Stefanova, N.; Atanasova, A.; Danguleva, A.; Ivanova, G.; Karapetkov, N.; Rumyan, N.; et al. Antimicrobial activity and antibiotic susceptibility of Lactobacillus and Bifidobacterium spp. intended for use as starter and probiotic cultures. Biotechnol. Biotechnol. Equip. 2014, 29, 84–91. [Google Scholar] [CrossRef]
- Abushelaibi, A.; Al-Mahadin, S.; El-Tarabily, K.; Shah, N.P.; Ayyash, M. Characterization of potential probiotic lactic acid bacteria isolated from camel milk. LWT 2017, 79, 316–325. [Google Scholar] [CrossRef]
- Ghanbari, M.; Jami, M. Lactic Acid Bacteria and Their Bacteriocins: A Promising Approach to Seafood Biopreservation. Intech 2013, 32, 381–404. [Google Scholar] [CrossRef]
- Bromberg, R.; Moreno, I.; Zaganini, C.L.; Delboni, R.R.; De Oliveira, J. Isolation of bacteriocin-producing lactic acid bacteria from meat and meat products and its spectrum of inhibitory activity. Braz. J. Microbiol. 2004, 35, 137–144. [Google Scholar] [CrossRef]
- Wayah, S.B.; Philip, K. Pentocin MQ1: A Novel, Broad-Spectrum, Pore-Forming Bacteriocin From Lactobacillus pentosus CS2 With Quorum Sensing Regulatory Mechanism and Biopreservative Potential. Front. Microbiol. 2018, 9, 564. [Google Scholar] [CrossRef]
- Agriopoulou, S.; Stamatelopoulou, E.; Sachadyn-Król, M.; Varzakas, T. Lactic Acid Bacteria as Antibacterial Agents to Extend the Shelf Life of Fresh and Minimally Processed Fruits and Vegetables: Quality and Safety Aspects. Microorganisms 2020, 8, 952. [Google Scholar] [CrossRef]
- Bungenstock, L.; Abdulmawjood, A.; Reich, F. Suitability of lactic acid bacteria and deriving antibacterial preparations to enhance shelf-life and consumer safety of emulsion type sausages. Food Microbiol. 2021, 94, 103673. [Google Scholar] [CrossRef] [PubMed]
- De Martinis, E.C.; Públio, M.R.; Santarosa, P.R.; Freitas, F.Z. Antilisterial activity of lactic acid bacteria isolated from vacuum-packaged brazilian meat and meat products. Braz. J. Microbiol. 2001, 32, 32–37. [Google Scholar] [CrossRef]
- Łaszkiewicz, B.; Szymański, P.; Zielińska, D.; Kołożyn-Krajewska, D. Application of Lactiplantibacillus plantarum SCH1 for the Bioconservation of Cooked Sausage Made from Mechanically Separated Poultry Meat. Appl. Sci. 2021, 11, 1576. [Google Scholar] [CrossRef]
- Huertas, R.A.P. Bacterias acido lacticas:papel funcional en los alimentos. Fac. Cienc. Agropecu. 2010, 8, 95–105. Available online: http://www.scielo.org.co/pdf/bsaa/v8n1/v8n1a12.pdf (accessed on 28 July 2021).
- Magala, M.; Kohajdová, Z.; Karovičová, J.; Greifová, M.; Greif, G. Application of Lactic Acid Bacteria as Starter Culture for Tarhana Fermentation. J. Microbiol. Biotechnol. Food Sci. 2014, 3, 498–504. [Google Scholar]
- Purohit, A.; Mohan, A. Antimicrobial effects of pyruvic and succinic acids on Salmonella survival in ground chicken. LWT 2019, 116, 108596. [Google Scholar] [CrossRef]
- Moradi, M.; Molaei, R.; Guimarães, J.T. A review on preparation and chemical analysis of postbiotics from lactic acid bacteria. Enzym. Microb. Technol. 2021, 143, 109722. [Google Scholar] [CrossRef]
- Lü, X.; Hu, P.; Dang, Y.; Liu, B. Purification and partial characterization of a novel bacteriocin produced by Lactobacillus casei TN-2 isolated from fermented camel milk (Shubat) of Xinjiang Uygur Autonomous region, China. Food Control 2014, 43, 276–283. [Google Scholar] [CrossRef]
- Castilho, N.P.A.; Colombo, M.; De Oliveira, L.L.; Todorov, S.D.; Nero, L.A. Lactobacillus curvatus UFV-NPAC1 and other lactic acid bacteria isolated from calabresa, a fermented meat product, present high bacteriocinogenic activity against Listeria monocytogenes. BMC Microbiol. 2019, 19, 63. [Google Scholar] [CrossRef]
- Vásquez, S.M.; Suárez, H.; Zapata, S. Utilización de sustancias antimicrobianas producidas por bacterias acido lácticas en la conservación de la carne. Rev. Chil. Nutr. 2009, 36, 64–71. [Google Scholar] [CrossRef]
- Pérez-Chabela, M.D.L.; Totosaus, A.; Guerrero, I. Evaluation of thermotolerant capacity of lactic acid bacteria isolated from commercial sausages and the effects of their addition on the quality of cooked sausages. Food Sci. Technol. 2008, 28, 132–138. [Google Scholar] [CrossRef]
- Kargozari, M.; Moini, S.; Basti, A.A.; Emam-Djomeh, Z.; Gandomi, H.; Martin, I.R.; Ghasemlou, M.; Carbonell-Barrachina, Á.A. Effect of autochthonous starter cultures isolated from Siahmazgi cheese on physicochemical, microbiological and volatile compound profiles and sensorial attributes of sucuk, a Turkish dry-fermented sausage. Meat Sci. 2014, 97, 104–114. [Google Scholar] [CrossRef] [PubMed]
- Abhari, K.; Jafarpour, D.; Shekarforoush, S. Effects of In-Package Pasteurization on Preventing Spoilage in Emulsion Vacuum Packaged Sausages during Refrigerated Storage. Food Raw Mater. 2018, 6, 40–46. [Google Scholar] [CrossRef]
- Arras, W.; Hussain, A.; Hausler, R.; Guiot, S. Mesophilic, thermophilic and hyperthermophilic acidogenic fermentation of food waste in batch: Effect of inoculum source. Waste Manag. 2019, 87, 279–287. [Google Scholar] [CrossRef] [PubMed]

| LAB Strain | Identification | LAB Strain | Identification |
|---|---|---|---|
| SB3 | Lactobacillus sakei (MW073315) | SB112 | Lactobacillus buchneri (99.8%) 1 |
| SB5 | Lactobacillus sakei (MW073316) | CB26 | Weissella confusa (MW073317) |
| SB17 | Lactobacillus plantarum (MW073312) | C12 | Enterococcus faecalis (MW073313) |
| SB99 | Lactococcus lactis (96%) 1 | C34 | Pediococcus acidilactici (82%) 1 |
| SB100 | Weissella confusa (MW073314) | C54 | Lactococcus garvieae (MW073318) |
| INGREDIENT | Control (Nitrite Salt) (C2 + N) | Treatment 1 and 2 | Control (−Nitrite Salt) (C1 − N) | Treatments 3 and 4 |
|---|---|---|---|---|
| Water (ice) | 48.17 | 48.17 | 48.26 | 48.26 |
| Pulverized garlic | 4.82 | 4.82 | 4.83 | 4.83 |
| Cassava starch | 8.03 | 8.03 | 8.04 | 8.04 |
| Ascorbic acid | 0.96 | 0.96 | 0.97 | 0.97 |
| Beef (ground) | 289.02 | 289.02 | 289.58 | 289.58 |
| Scallions | 48.17 | 48.17 | 48.26 | 48.26 |
| Orange coloring | 0.32 | 0.32 | 0.32 | 0.32 |
| Chorizo seasoning | 6.74 | 6.74 | 6.76 | 6.76 |
| Monosodium glutamate | 0.80 | 0.80 | 0.80 | 0.80 |
| Pork fat | 81.89 | 81.89 | 82.05 | 82.05 |
| Liquid smoke (mL) | 1.45 | 1.45 | 1.45 | 1.45 |
| Nitrous salts ** | 0.96 | 0.96 | 0.00 | 0.00 |
| Soy protein | 6.42 | 6.42 | 6.44 | 6.44 |
| Refined salt | 2.25 | 2.25 | 2.25 | 2.25 |
| Inoculum | 0.00 | 15.00 | 0.00 | 15.00 |
| Strain | Tetracycline | Amoxicillin | Penicillin | Ampicillin | LAT |
|---|---|---|---|---|---|
| SB3 | R | S | S | S | DL |
| SB5 | S | S | S | S | DL |
| SB17 | S | S | S | S | L (+) |
| SB99 | S | S | S | S | L (+) |
| SB100 | S | S | S | S | L (+) |
| SB112 | R | S | S | S | L (+) |
| C12 | S | S | S | S | L (+) |
| C34 | S | S | S | S | L (+) |
| C54 | S | S | S | S | L (+) |
| CB26 | R | S | S | S | L (+) |
| Strain | Fraction A | Fraction B | ||
|---|---|---|---|---|
| L. monocytogenes | S. aureus | S. marcescens | ||
| SB112 | 3.77 | − | − | − |
| C12 | 4.53 | − | − | − |
| SB17 | 3.87 | − | − | − |
| SB5 | 4.29 | − | − | − |
| CB26 | 4.53 | − | − | − |
| SB99 | 4.72 | + | + | − |
| C54 | 4.39 | − | − | − |
| C34 | 4.48 | − | − | − |
| SB3 | 4.57 | − | − | − |
| SB100 | 4.37 | − | − | − |
| Sample | Citric (mg/L) | Succinic (mg/L) | Lactic (mg/L) | Acetic (mg/L) | Propionic (mg/L) | Ethanol (%) |
|---|---|---|---|---|---|---|
| SB3 | ND | 124.13 ± 0.03 | 7801.76 ± 0.01 | ND | ND | 0.22 |
| SB5 | ND | 151.47 ± 0.1 | 7704.21 ± 0.01 | ND | ND | 0.20 |
| SB17 | ND | 157.90 ± 0.1 | 1871.67 ± 0.01 | ND | 130.35 ± 0.002 | 0.67 |
| SB99 | ND | 160.89 ± 0.01 | 13,613.91 ± 0.01 | 94.36 ± 0.01 | ND | 0.23 |
| SB100 | ND | 156.00 ± 0.3 | 8828.47 ± 0.002 | ND | ND | 0.64 |
| C12 | ND | 163.49 ± 0.01 | 7663.85 ± 0.01 | 1885.77 ± 0.007 | ND | 0.49 |
| C34 | ND | 148.26 ± 0.6 | 5719.51 ± 0.03 | ND | ND | 0.22 |
| C54 | ND | 100.82 ± 0.15 | 5070.16 ± 0.06 | 4.71 ± 0.001 | ND | 0.22 |
| CB26 | ND | 159.54 ± 0.01 | 7823.55 ± 0.01 | 2000.29 ± 0.01 | ND | 0.57 |
| Strains | Protein Concentration (mg/L) |
|---|---|
| SB3 | 152.462 |
| SB5 | 155.54 |
| SB17 | 170.15 |
| SB99 | 142.46 |
| SB100 | 211.69 |
| CB26 | 159.89 |
| C12 | 168.61 |
| C34 | 157.85 |
| C54 | 147.85 |
| Control | 211.69 |
Publisher’s Note: MDPI stays neutral with regard to jurisdictional claims in published maps and institutional affiliations. |
© 2021 by the authors. Licensee MDPI, Basel, Switzerland. This article is an open access article distributed under the terms and conditions of the Creative Commons Attribution (CC BY) license (https://creativecommons.org/licenses/by/4.0/).
Share and Cite
Lucumi-Banguero, R.S.; Ramírez-Toro, C.; Bolívar, G.A. Potential Use of Lactic Acid Bacteria with Pathogen Inhibitory Capacity as a Biopreservative Agent for Chorizo. Processes 2021, 9, 1582. https://doi.org/10.3390/pr9091582
Lucumi-Banguero RS, Ramírez-Toro C, Bolívar GA. Potential Use of Lactic Acid Bacteria with Pathogen Inhibitory Capacity as a Biopreservative Agent for Chorizo. Processes. 2021; 9(9):1582. https://doi.org/10.3390/pr9091582
Chicago/Turabian StyleLucumi-Banguero, Ruby Stella, Cristina Ramírez-Toro, and German A. Bolívar. 2021. "Potential Use of Lactic Acid Bacteria with Pathogen Inhibitory Capacity as a Biopreservative Agent for Chorizo" Processes 9, no. 9: 1582. https://doi.org/10.3390/pr9091582
APA StyleLucumi-Banguero, R. S., Ramírez-Toro, C., & Bolívar, G. A. (2021). Potential Use of Lactic Acid Bacteria with Pathogen Inhibitory Capacity as a Biopreservative Agent for Chorizo. Processes, 9(9), 1582. https://doi.org/10.3390/pr9091582







